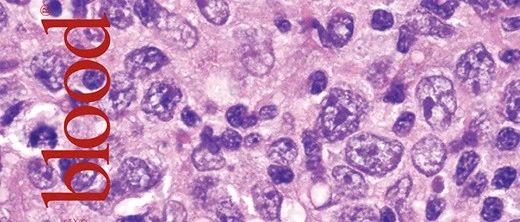

每天排便几次算正常?大便出现四种症状可能是肠癌征兆,别大意!
每天排便几次算正常?对于很多人而言,宝宝心里的苦,没人了解。最易引起排便次数改变的就是便秘和腹泻,对于便秘的患者而言,每周排便的次数少于3次,同时还伴有明显的排便困难和大便干结,对于腹泻的患者而言,每天排便的次数超过了3次以上,而且粪质稀薄,粪便的含水量超过了85%。对于大多数健康人而言,他们的排便频率是每天1次,而且排便时间会比较固定,往往是在晨起或早餐后,之所以这样,是因为晨起后结肠的蠕动能力会增强,正是在肠蠕动的作用下,大便才会一路朝前,最终排出肛门。早餐后出现便意,这得益于胃结肠反射。胃结肠反射是指进食以后胃充盈可以反射性地引起结肠蠕动增加,从而将内容物推向直肠,引起排便反射。...